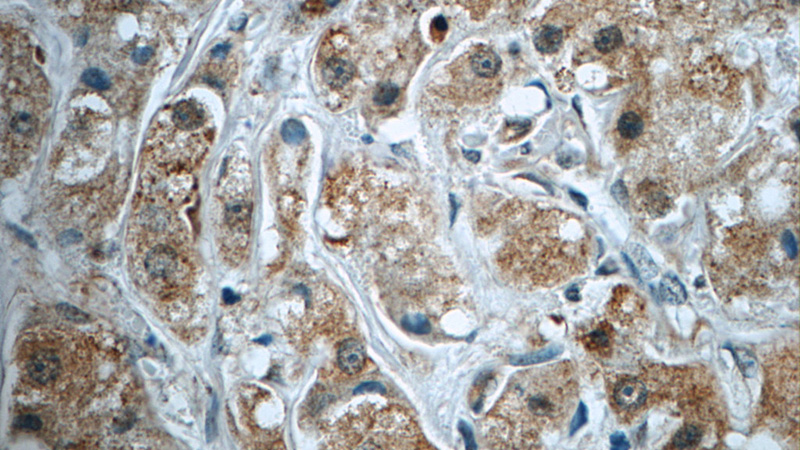
Immunohistochemistry of paraffin-embedded human breast cancer tissue slide using Catalog No:115658(SQLE Antibody) at dilution of 1:50 (under 40x lens)

-
Product Name
SQLE antibody
- Documents
-
Description
SQLE Rabbit Polyclonal antibody. Positive WB detected in A549 cells, HEK-293 cells. Positive IP detected in A549 cells. Positive IHC detected in human breast cancer tissue, human prostate cancer tissue. Positive IF detected in PC-3 cells. Observed molecular weight by Western-blot: 64kd
-
Tested applications
ELISA, WB, IHC, IP, IF
-
Species reactivity
Human,Mouse,Rat; other species not tested.
-
Alternative names
ERG1 antibody; FLJ30795 antibody; SQLE antibody; squalene epoxidase antibody; Squalene monooxygenase antibody
- Immunogen
-
Isotype
Rabbit IgG
-
Preparation
This antibody was obtained by immunization of SQLE recombinant protein (Accession Number: NM_003129). Purification method: Antigen affinity purified.
-
Clonality
Polyclonal
-
Formulation
PBS with 0.1% sodium azide and 50% glycerol pH 7.3.
-
Storage instructions
Store at -20℃. DO NOT ALIQUOT
-
Applications
Recommended Dilution:
WB: 1:200-1:2000
IP: 1:200-1:1000
IHC: 1:20-1:200
IF: 1:20-1:200
-
Validations

A549 cells were subjected to SDS PAGE followed by western blot with Catalog No:115658(SQLE antibody) at dilution of 1:300

IP Result of anti-SQLE (IP:Catalog No:115658, 3ug; Detection:Catalog No:115658 1:300) with A549 cells lysate 920ug.

Immunohistochemistry of paraffin-embedded human breast cancer tissue slide using Catalog No:115658(SQLE Antibody) at dilution of 1:50 (under 10x lens)
Immunohistochemistry of paraffin-embedded human breast cancer tissue slide using Catalog No:115658(SQLE Antibody) at dilution of 1:50 (under 40x lens)

Immunofluorescent analysis of PC-3 cells using Catalog No:115658(SQLE Antibody) at dilution of 1:50 and Alexa Fluor 488-congugated AffiniPure Goat Anti-Rabbit IgG(H+L)
-
Background
SQLE, also named as ERG1, SE and SM, belongs to the squalene monooxygenase family. It catalyzes the first oxygenation step in cholesterol synthesis, acting on squalene before cyclization into the basic steroid structure. SQLE may serve as a flux-controlling enzyme beyond 3-hydroxy-3-methylglutaryl-coenzyme A reductase (HMGR, considered as rate limiting). It is also posttranslationally regulated by cholesterol-dependent proteasomal degradation.(PMID:21356516) The MW of SQLE is about 64kd.
-
References
- Gill S, Stevenson J, Kristiana I, Brown AJ. Cholesterol-dependent degradation of squalene monooxygenase, a control point in cholesterol synthesis beyond HMG-CoA reductase. Cell metabolism. 13(3):260-73. 2011.
- Kristiana I, Luu W, Stevenson J. Cholesterol through the looking glass: ability of its enantiomer also to elicit homeostatic responses. The Journal of biological chemistry. 287(40):33897-904. 2012.
- Suzuki R, Ferris HA, Chee MJ, Maratos-Flier E, Kahn CR. Reduction of the cholesterol sensor SCAP in the brains of mice causes impaired synaptic transmission and altered cognitive function. PLoS biology. 11(4):e1001532. 2013.
- Foresti O, Ruggiano A, Hannibal-Bach HK, Ejsing CS, Carvalho P. Sterol homeostasis requires regulated degradation of squalene monooxygenase by the ubiquitin ligase Doa10/Teb4. eLife. 2:e00953. 2013.
- Zelcer N, Sharpe LJ, Loregger A. The E3 ubiquitin ligase MARCH6 degrades squalene monooxygenase and affects 3-hydroxy-3-methyl-glutaryl coenzyme A reductase and the cholesterol synthesis pathway. Molecular and cellular biology. 34(7):1262-70. 2014.
- Suzuki R, Lee K, Jing E. Diabetes and insulin in regulation of brain cholesterol metabolism. Cell metabolism. 12(6):567-79. 2010.
- Honsho M, Abe Y, Fujiki Y. Dysregulation of Plasmalogen Homeostasis Impairs Cholesterol Biosynthesis. The Journal of biological chemistry. 290(48):28822-33. 2015.
- Loregger A, Cook EC, Nelson JK. A MARCH6 and IDOL E3 Ubiquitin Ligase Circuit Uncouples Cholesterol Synthesis from Lipoprotein Uptake in Hepatocytes. Molecular and cellular biology. 36(2):285-94. 2015.
Related Products / Services
Please note: All products are "FOR RESEARCH USE ONLY AND ARE NOT INTENDED FOR DIAGNOSTIC OR THERAPEUTIC USE"
